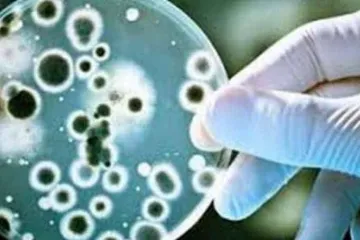

Մերձավոր Արևելքում պшտերազմը կարող է Ուկրաինային թողնել առանց հակաoդային պաշտպանnւթյան hրթիռների հայ...
Մերձավոր Արևելքում պшտերազմը կարող է Ուկրաինային թողնել առանց հակաoդային պաշտպանnւթյան hրթիռների հայ...
1
 2–րդ դասարանցի երեխան «որովայնի սալջարդ» ախտորոշմամբ տեղափոխվել է ԲԿ
2–րդ դասարանցի երեխան «որովայնի սալջարդ» ախտորոշմամբ տեղափոխվել է ԲԿ
2
 Իսրայելի պաշտպանության բանակը hարվածներ է hասցրել Իրանի և Լիբանանի ավելի քան 200 օբյեկտի
Իսրայելի պաշտպանության բանակը hարվածներ է hասցրել Իրանի և Լիբանանի ավելի քան 200 օբյեկտի
3
 Այսօր մետրոյում Փաշինյանին պատասխանող Արցախցի կինը պարզապես հիացմունքի է արժանի. Ավետիք Չալաբյան
Այսօր մետրոյում Փաշինյանին պատասխանող Արցախցի կինը պարզապես հիացմունքի է արժանի. Ավետիք Չալաբյան
4
 Իրանը Բրիտանիայից պահանջել է զերծ մնալ ԱՄՆ-ին և Իսրայելին աջակցելուց
Իրանը Բրիտանիայից պահանջել է զերծ մնալ ԱՄՆ-ին և Իսրայելին աջակցելուց
5
 Իսրայելի պաշտպանության նախարարը հաստատել է, որ Իրանի հետախուզության նախարար Իսմայիլ Խաթիբը uպանվել է
Իսրայելի պաշտպանության նախարարը հաստատել է, որ Իրանի հետախուզության նախարար Իսմայիլ Խաթիբը uպանվել է
6
 Իրանը hարվածներ չի hասցնում քաղաքացիական օբյեկտներին. Արաղչի
Իրանը hարվածներ չի hասցնում քաղաքացիական օբյեկտներին. Արաղչի
7
 Երևան-Սևան ճանապարհին բախվել են «Opel Zafira»-ն և «Opel Astra»-ն
Երևան-Սևան ճանապարհին բախվել են «Opel Zafira»-ն և «Opel Astra»-ն
8
 Դու ո՞վ ես, քեզ դիմեցի 2018 թվականից, բան չարեցիր, քաղցկեղս դարձրիր 4-րդ ստադիա. քաղաքացին՝ Փաշինյան...
Դու ո՞վ ես, քեզ դիմեցի 2018 թվականից, բան չարեցիր, քաղցկեղս դարձրիր 4-րդ ստադիա. քաղաքացին՝ Փաշինյան...
9
 Հայաստանը լինելու է ուժեղ, արժանապատիվ, խաղաղ և իր ապագան ինքնուրույն կերտող պետություն․ Իրինա Յոլյա...
Հայաստանը լինելու է ուժեղ, արժանապատիվ, խաղաղ և իր ապագան ինքնուրույն կերտող պետություն․ Իրինա Յոլյա...
10
Լրահոս
 Ալեն Սիմոնյանը խիստ նախազգուշացրել է վարորդներին
Ալեն Սիմոնյանը խիստ նախազգուշացրել է վարորդներին
 Բզկտված ԱՐՑԱԽ. ԶԱՐԴԱՆԱՇԵՆ. Արտակ Զաքարյան
Բզկտված ԱՐՑԱԽ. ԶԱՐԴԱՆԱՇԵՆ. Արտակ Զաքարյան
 Բզկտված ԱՐՑԱԽ. ՄԱԴԱԹԱՇԵՆ. Արտակ Զաքարյան
Բզկտված ԱՐՑԱԽ. ՄԱԴԱԹԱՇԵՆ. Արտակ Զաքարյան
 Նորընտիր ՄԻՊ-ը քամահրանքով էր պատասխանում մեր հարցերին, ցույց տալիս՝ ես գիտեմ՝ որ կողմում ով է նստած. Աննա Մկրտչյան
Նորընտիր ՄԻՊ-ը քամահրանքով էր պատասխանում մեր հարցերին, ցույց տալիս՝ ես գիտեմ՝ որ կողմում ով է նստած. Աննա Մկրտչյան
 Վերսկսում ենք «Հանուն Կյանքի» մարդասիրական ծրագիրը. Նարինե Մանուկյան
Վերսկսում ենք «Հանուն Կյանքի» մարդասիրական ծրագիրը. Նարինե Մանուկյան
 Omicron-ի դեպքում ՊՇՌ թեստը դրական է միայն հիվանդության երկրորդ էտապում. Աշոտ Բարսեղյան
Omicron-ի դեպքում ՊՇՌ թեստը դրական է միայն հիվանդության երկրորդ էտապում. Աշոտ Բարսեղյան
 Խանդ, սեր, բաժանում. հունվարի 26-ի ձեր ռոմանտիկ հորոսկոպը
Խանդ, սեր, բաժանում. հունվարի 26-ի ձեր ռոմանտիկ հորոսկոպը
 ԱԺ նախագահի խոսնակը հորդորել է հերքել տարածվող տեղեկությունը
ԱԺ նախագահի խոսնակը հորդորել է հերքել տարածվող տեղեկությունը
 Ամեն ինչ տեղը գցելու ժամանակը դեռ կգա. Տիգրան Աբրահամյան
Ամեն ինչ տեղը գցելու ժամանակը դեռ կգա. Տիգրան Աբրահամյան
 Այգեպարի գերեզմանատան մոտ «Isuzu»-ն դուրս է եկել ճանապարհից եւ մոտ 35 մ գլորվել ձորը. կա զոհ եւ 3 վիրավոր
Այգեպարի գերեզմանատան մոտ «Isuzu»-ն դուրս է եկել ճանապարհից եւ մոտ 35 մ գլորվել ձորը. կա զոհ եւ 3 վիրավոր
 ՆԱՏՕ-ն (ԱՄՆ, Թուրքիա …) անկախ ազգերի և ինքնիշխան պետությունների համար կործանիչ դիկտատոր է
ՆԱՏՕ-ն (ԱՄՆ, Թուրքիա …) անկախ ազգերի և ինքնիշխան պետությունների համար կործանիչ դիկտատոր է
 «Նիկոլ Փաշինյանի և Իլհամ Ալիևի շահերը համընկնում են». Արթուր Ղազինյան
«Նիկոլ Փաշինյանի և Իլհամ Ալիևի շահերը համընկնում են». Արթուր Ղազինյան
 Չոբանյանը խոստանում է նպաստել Հայաստանում առաջատար տեխնոլոգիաների ոլորտի զարգացմանը
Չոբանյանը խոստանում է նպաստել Հայաստանում առաջատար տեխնոլոգիաների ոլորտի զարգացմանը
 Ամերիաբանկ. Հայաստանի առաջատար հարկատու բանկը՝ 2021 թվականի տվյալներով
Ամերիաբանկ. Հայաստանի առաջատար հարկատու բանկը՝ 2021 թվականի տվյալներով
 Հակոբ Սիմիդյանը` ՇՄ նոր փոխնախարարի մասին
Հակոբ Սիմիդյանը` ՇՄ նոր փոխնախարարի մասին
 ՆԱՏՈ-ի զորքերը Կիևի մետրոյում
ՆԱՏՈ-ի զորքերը Կիևի մետրոյում
 Ուկրաինայի եւ ՌԴ-ի միջեւ ճգնաժամը Հարավային Կովկասում կարող է նոր պայթյունավտանգ իրավիճակ ստեղծել. Տիգրան Աբրահամյան
Ուկրաինայի եւ ՌԴ-ի միջեւ ճգնաժամը Հարավային Կովկասում կարող է նոր պայթյունավտանգ իրավիճակ ստեղծել. Տիգրան Աբրահամյան
 Կալանքը պատիժ է դարձել Փաշինյանի ձեռքին․ հաշվեհարդար «Պատրոն Դավո»-ի նկատմամբ
Կալանքը պատիժ է դարձել Փաշինյանի ձեռքին․ հաշվեհարդար «Պատրոն Դավո»-ի նկատմամբ
 Դժբախտություն Ավետ Բարսեղյանի ընտանիքում. նա մեծ կորուստ է ունեցել
Դժբախտություն Ավետ Բարսեղյանի ընտանիքում. նա մեծ կորուստ է ունեցել
 Ադրբեջանցիները ոչխարները չվերադարձնելու նոր պատճառ են գտել
Ադրբեջանցիները ոչխարները չվերադարձնելու նոր պատճառ են գտել
 «Որոշեցի և կտրեցի»․ Ալինա Մարտիրոսյանի ոճափոխությունը
«Որոշեցի և կտրեցի»․ Ալինա Մարտիրոսյանի ոճափոխությունը
 Սարսափելի ծիծաղ է առաջացնում ՄԻՊ թեկնածուի այն հայտարարությունը, որ «Հայաստանում քաղբանտարկյալներ չկան». Անժելա Նալբանդյան
Սարսափելի ծիծաղ է առաջացնում ՄԻՊ թեկնածուի այն հայտարարությունը, որ «Հայաստանում քաղբանտարկյալներ չկան». Անժելա Նալբանդյան
 Ինչպես կանխատեսում էի՝ շաբաթ և կիրակի օրերին բոլորի շրջանառությունը կեսից ավելի պակասել է. Աշոտ Բարսեղյան
Ինչպես կանխատեսում էի՝ շաբաթ և կիրակի օրերին բոլորի շրջանառությունը կեսից ավելի պակասել է. Աշոտ Բարսեղյան
 Երկար ժամանակով լույս չի լինելու Երևանում և 4 մարզերում
Երկար ժամանակով լույս չի լինելու Երևանում և 4 մարզերում
 Facebook-ը, Zoom-ը, Uber-ը, Netflix-ը, Quora-ն օգտվում են հայկական ստարտափի պլատֆորմից. նոր հնարավորություններ՝ Հայաստանի ՏՏ մասնագետների համար. «Փաստ»
Facebook-ը, Zoom-ը, Uber-ը, Netflix-ը, Quora-ն օգտվում են հայկական ստարտափի պլատֆորմից. նոր հնարավորություններ՝ Հայաստանի ՏՏ մասնագետների համար. «Փաստ»
 Արատավոր երևույթների ու մեխանիզմների վերադարձը. «Փաստ»
Արատավոր երևույթների ու մեխանիզմների վերադարձը. «Փաստ»
 Արմեն Սարգսյանը խուսափում է հերթական զիջումների մասը դառնալ. Աննա Գրիգորյան
Արմեն Սարգսյանը խուսափում է հերթական զիջումների մասը դառնալ. Աննա Գրիգորյան
 Ադրբեջանական բանակը մեկ օրում երկու զինծառայող է կորցրել
Ադրբեջանական բանակը մեկ օրում երկու զինծառայող է կորցրել
 Երկիրը որբի գլուխ է արդեն 3,5 տարի․ Արթուր Ղազինյան
Երկիրը որբի գլուխ է արդեն 3,5 տարի․ Արթուր Ղազինյան
 Հակառակորդը կեսգիշերին կրակոցներ է արձակել
Հակառակորդը կեսգիշերին կրակոցներ է արձակել
 Հայաստանում Ժողովրդավարությունը սպանվել է հենց ժողովրդավարության «մարտիկների» ձեռքերով. Արտակ Զաքարյան
Հայաստանում Ժողովրդավարությունը սպանվել է հենց ժողովրդավարության «մարտիկների» ձեռքերով. Արտակ Զաքարյան
 Թշնամին Գեղարքունիքում ազդեցիկ լույսերով գիշերվա ժամերին թիրախավորում է քաղաքացիների տները. Թագուհի Թովմասյան
Թշնամին Գեղարքունիքում ազդեցիկ լույսերով գիշերվա ժամերին թիրախավորում է քաղաքացիների տները. Թագուհի Թովմասյան
 Բզկտված ԱՐՑԱԽ. ՋՐԱՂԱՑՆԵՐ. Արտակ Զաքարյան
Բզկտված ԱՐՑԱԽ. ՋՐԱՂԱՑՆԵՐ. Արտակ Զաքարյան
 Վաղո՛, ո՞րն է քո հայրենիքը․ Աննա Գրիգորյանը «չծառայած», բայց բանակի մասին խոսող Վաղարշակ Հակոբյանին
Վաղո՛, ո՞րն է քո հայրենիքը․ Աննա Գրիգորյանը «չծառայած», բայց բանակի մասին խոսող Վաղարշակ Հակոբյանին
 Ո՞ւմ պասերի կարիքն ունեք, միգուցե, Էրդողանի՞, Ալիևի՞. Արթուր Ղազինյանը՝ Նիկոլ Փաշինյանին
Ո՞ւմ պասերի կարիքն ունեք, միգուցե, Էրդողանի՞, Ալիևի՞. Արթուր Ղազինյանը՝ Նիկոլ Փաշինյանին
 Հարգանք չեք վայելում․ իշխանությունը անձնական իրավապաշտպան կստանա, եթե Դուք ընտրվեք ՄԻՊ պաշտոնում. Ղազինյան
Հարգանք չեք վայելում․ իշխանությունը անձնական իրավապաշտպան կստանա, եթե Դուք ընտրվեք ՄԻՊ պաշտոնում. Ղազինյան
 Մեր երկրում քաղբանտարկյալներ կա՞ն. Աննա Գրիգորյանը` ՄԻՊ թեկնածուին
Մեր երկրում քաղբանտարկյալներ կա՞ն. Աննա Գրիգորյանը` ՄԻՊ թեկնածուին
 Գոռ Եփրեմյանի և սիրելիի սիրառատ լուսանկարները փոքրիկ երեխայի հետ
Գոռ Եփրեմյանի և սիրելիի սիրառատ լուսանկարները փոքրիկ երեխայի հետ
 Հիմա մի լայքով կամ մի ստատուսով աշխատանքի են ընդունում և ազատում. Աննա Մկրտչյան
Հիմա մի լայքով կամ մի ստատուսով աշխատանքի են ընդունում և ազատում. Աննա Մկրտչյան
 Իշխանության ներկայացուցիչները չեն բարձրաձայնում, որ ՌԴ-ն մեր ռազմավարական դաշնակիցն է, բայց գնում են Ռուսաստան և, Փաշինյանի բառապաշարով ասեմ, «կոշիկ են լիզում»․ Վանեցյան
Իշխանության ներկայացուցիչները չեն բարձրաձայնում, որ ՌԴ-ն մեր ռազմավարական դաշնակիցն է, բայց գնում են Ռուսաստան և, Փաշինյանի բառապաշարով ասեմ, «կոշիկ են լիզում»․ Վանեցյան
 Ամբիոնից «շնաբարո դուրսպրծուկ» և այլ արտահայտություններն են հնչել. Ղազինյանը՝ ՄԻՊ նոր թեկնածուին
Ամբիոնից «շնաբարո դուրսպրծուկ» և այլ արտահայտություններն են հնչել. Ղազինյանը՝ ՄԻՊ նոր թեկնածուին
 Առանց ընդդիմության ձայների առաջին փուլով Հանրապետության նախագահ ընտրվել չի կարող. Ռոբերտ Հայրապետյան
Առանց ընդդիմության ձայների առաջին փուլով Հանրապետության նախագահ ընտրվել չի կարող. Ռոբերտ Հայրապետյան
 Տեսչական մարմինը չի կարող առողջապահության նախարարի հաստատած սանիտարական կանոնի չպահպանման համար տուգանել ձեզ. իրավաբան
Տեսչական մարմինը չի կարող առողջապահության նախարարի հաստատած սանիտարական կանոնի չպահպանման համար տուգանել ձեզ. իրավաբան
 Չորս տարվա ակտիվ ես կասեի անգամ գերակտիվ աշխատանքի արդյունքները. Կարեն Ավագյան
Չորս տարվա ակտիվ ես կասեի անգամ գերակտիվ աշխատանքի արդյունքները. Կարեն Ավագյան
 Խանդ, սեր, բաժանում. հունվարի 24-ի ձեր ռոմանտիկ հորոսկոպը
Խանդ, սեր, բաժանում. հունվարի 24-ի ձեր ռոմանտիկ հորոսկոպը
 Հանրային հետաքրքրություն ներկայացնող հարցեր, որոնք օր առաջ պետք է պատասխան ստանան. Ռոբերտ Հայրապետյան
Հանրային հետաքրքրություն ներկայացնող հարցեր, որոնք օր առաջ պետք է պատասխան ստանան. Ռոբերտ Հայրապետյան
 Այս գրառման իմաստը «բա որ ասում էի» ոճի անձնական մխիթարանքը չէ. Արմեն Աշոտյան
Այս գրառման իմաստը «բա որ ասում էի» ոճի անձնական մխիթարանքը չէ. Արմեն Աշոտյան
 Փորձագետները չեն ակնկալում, որ Covid-ը լիովին կվերանա մեր կյանքից. Կարեն Ավագյան
Փորձագետները չեն ակնկալում, որ Covid-ը լիովին կվերանա մեր կյանքից. Կարեն Ավագյան
 Արցախի 75 տոկոսը հանձնել են ու «դմփ-դմփ-հու» են գոռում. Շարմազանով
Արցախի 75 տոկոսը հանձնել են ու «դմփ-դմփ-հու» են գոռում. Շարմազանով
Ոնց ստից և թուլամորթ պաշտոնավարեց, այդպիսի ստից և թուլամորթ տեքստով էլ հրաժարական տվեց. Արմեն Աշոտյան
Ոնց ստից և թուլամորթ պաշտոնավարեց, այդպիսի ստից և թուլամորթ տեքստով էլ հրաժարական տվեց. Արմեն Աշոտյան


